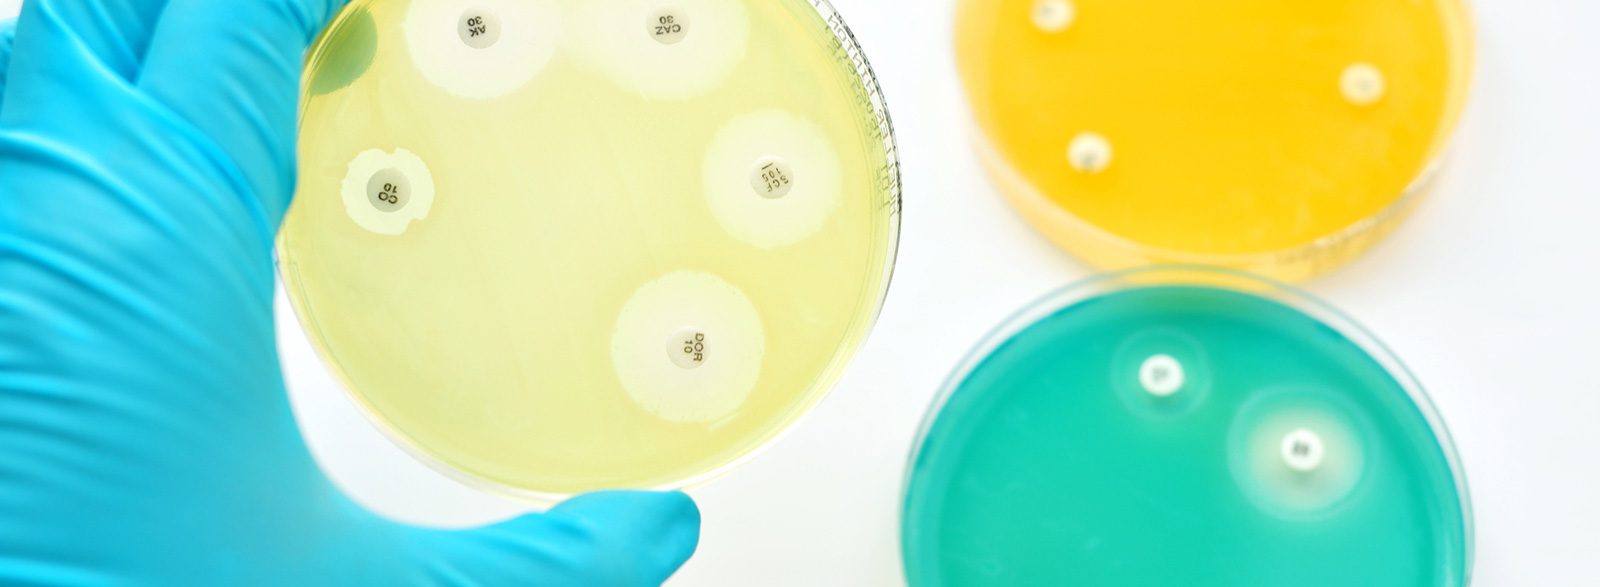

Mikrobiologie
Die Untersuchungen der Abteilung Mikrobiologie sind auf folgende Schwerpunkte gerichtet:
- Ermittlung des mikrobiologischen Status von Lebensmitteln sowie Nachweis pathogener Keime wie z.B. Salmonellen, Listeria monocytogenes und Campylobakter
- Sensorische Begutachtung
- Durchführung von Verlaufsuntersuchungen zur Ermittlung oder Kontrolle der Einhaltung des MHD`s bzw. des Verbrauchsdatums
- Durchführung der im Rahmen der Verordnung (EG) Nr. 2073/2005 über mikrobiologische Kriterien für Lebensmittel vorgeschriebenen mikrobiologischen Untersuchungen
- Mikrobiologische Wareneingangskontrollen für tierische oder pflanzliche Rohstoffe bzw. Halbfabrikate
- Mikrobiologische Überprüfung des Reinigungs- und Desinfektionszustandes von Geräten und Flächen
- Probenahme von Trinkwasser zur mikrobiologischen Untersuchung
- Mikrobiologische Untersuchung von Trinkwasser gemäß der aktuellen Trinkwasser-Verordnung
- Überprüfung der ausgewiesenen Handelsklassen bei frischem und tiefgefrorenem Geflügel sowie bei Eiern
- Prüfung von Eiern auf ihren Frischegrad (Luftkammerhöhe, Dotterindex, Haugheinheiten)